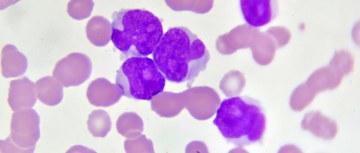
An image of Acute Myeloid Leukemia cells

During the height of COVID-19, HOPA's Investigational Drug Services (IDS) professionals were hard at work adapting how clinical trials are delivered. Through modifications to IDS workflows and platforms, HOPA's IDS Special Interest Group (SIG) identified a best-practice approach for patients who were involved in clinical trials during the pandemic - and that continue to help mitigate the crisis in clinical research today.
The paper was published in the American Journal of Health-System Pharmacy.
Authors: Heidi D Finnes, PharmD, BCOP, FHOPA; Berrie Child, PharmD, BCOP; Sean DeFrates, PharmD, BCOP; Katharine Kinsman, PharmD, BCOP, Andrew Thorne, PharmD, MS; Sarah Lentz, RPh, BCOP; Robin Lockhorst, PharmD, BCOP, BCPS; Jennifer Murphy, PharmD, BCOP, BCPS; Angela Urmanski, PharmD, BCOP; Sapna Amin, PharmD, BCOP; Hallie Barr, PharmD, BCOP; Sunanda Baviskar, RPh, MBA; Carrie Beckman, PharmD, BCPS, BCOP; Nicholas Chow, PharmD, BCOP; Megan Derba, PharmD; Marsha Erickson, PharmD; Emily Hennes, PharmD, BCOP; Heather Heisey, RPh; Rebecca Lau, PharmD, BCOP; Suwicha Limvorasak, PharmD, BCOP; Todd Luckritz, PharmD; Theresa Mays, PharmD, BCOP, FASHP; Chukwuemeka N Nzelibe, PharmD, MBA, BCOP; Tracy Romanowski, PharmD, MS; Camille Smith, PharmD, DPLA, CCRP; Debra Tesoro, RPh, BCOP; Katelyn Toeniskoetter, PharmD; and Krista Voytilla, PharmD, BCOP